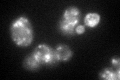
YKL004W
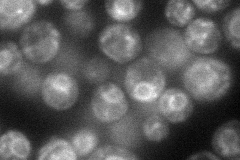
YKL004W
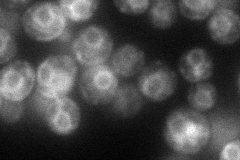
YKL004W
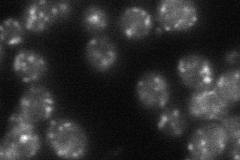
YKL004W
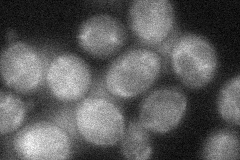
YKL004W
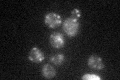
YKL004W

View description
Phosphatidylinositol:ceramide phosphoinositol transferase (IPC synthase), required for sphingolipid synthesis; can mutate to confer aureobasidin A resistance
Localization:
Intensity:
Fold change:
Significance:
-
C’ GFP library in SD
punctate53.1 -
N' NOP1pr-GFP in SD
ER,punctate67.4832 -
N' TEF2pr-mCherry in SD
ER,punctate65.0518 -
N' NATIVEpr-GFP in SD
punctate33.0177 -
N' TEF2pr-VC and Cyto-VN in SD
cytosol33.6266 -
C’ GFP library in SD+DTT

punctate34.440.64No -
C’ GFP library in SD+H2O2

punctate49.390.93No -
C’ GFP library in Starvation Media
punctate33.510.63No -
C’ GFP library on the background of Pup2-DaMP

punctate -
C’ GFP library on the background of CCT mutant

punctate54.40471.02452No
